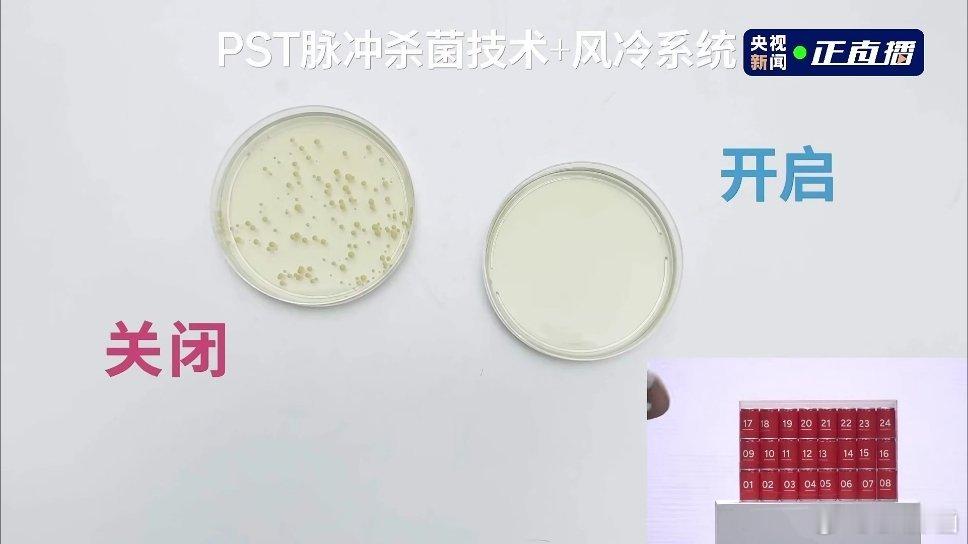

小鹏GX的产品经理跟何小鹏说这车的冰箱很大,可以放下一箱可乐,何小鹏第一反应是:“茅台一箱6瓶,这个我熟,可乐一箱是多少瓶?”刚刚现场演示了一下,不止能放一箱,能放32瓶小可乐!另外,这个冰箱还有除菌功能。新科技旗舰小鹏GX今晚预售央视称小鹏GX为科技大成之作



小鹏GX的产品经理跟何小鹏说这车的冰箱很大,可以放下一箱可乐,何小鹏第一反应是:“茅台一箱6瓶,这个我熟,可乐一箱是多少瓶?”刚刚现场演示了一下,不止能放一箱,能放32瓶小可乐!另外,这个冰箱还有除菌功能。新科技旗舰小鹏GX今晚预售央视称小鹏GX为科技大成之作